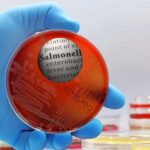
Bharat Biotech Paratyphi Vaccine

October 31, 2025: Gavaskar & Jemimah Rodrigues’s Musical Tease has created a huge buzz. And, It’s not every day that a cricket legend promises a duet if the national team wins a World Cup. But this isn’t every day.
After India’s stunning semi-final win over Australia in the Women’s World Cup 2025, Sunil Gavaskar has thrown down a challenge, not with the bat, but with a mic. If India lifts the trophy on Sunday, he says he’ll sing a song with Jemimah Rodrigues, who played a blinder to take India into the final.
“I’m game if she is,” Gavaskar said with a grin on Sports Today. “She’ll have her guitar, and I’ll sing along. We’ve done it once before, why not again?”
The duo first jammed at a BCCI awards night, surprising everyone with their impromptu performance. Gavaskar, never shy of a spotlight, recalled the moment fondly and said he’d love to recreate it—if Rodrigues is up for it.
And why wouldn’t she be? After all, she just played one of the greatest innings in Women’s World Cup history.
CWC25: Gavaskar’s Mic Drop Moment Awaits Jemimah Rodrigue’s Guitar
Jemimah Rodrigues remained unbeaten on 127 off 134 balls, guiding India to a record chase of 339 runs, the highest ever in a Women’s World Cup knockout. Her partnership with Harmanpreet Kaur (167 runs) was the backbone of India’s victory, and her calm finish sealed the deal.
Gavaskar also praised her fielding, pointing out two sharp runouts that kept Australia from running away with the game. “She reads the game brilliantly,” he said. “That’s the mark of someone who’s played in tough leagues and knows how to handle pressure.”
CWC25 Final countdown: South Africa awaits
India now faces South Africa in the final, and Gavaskar believes the team’s confidence and home advantage could be decisive. “They’re peaking at the right time,” he said. “If they keep this up, the trophy’s coming home.”